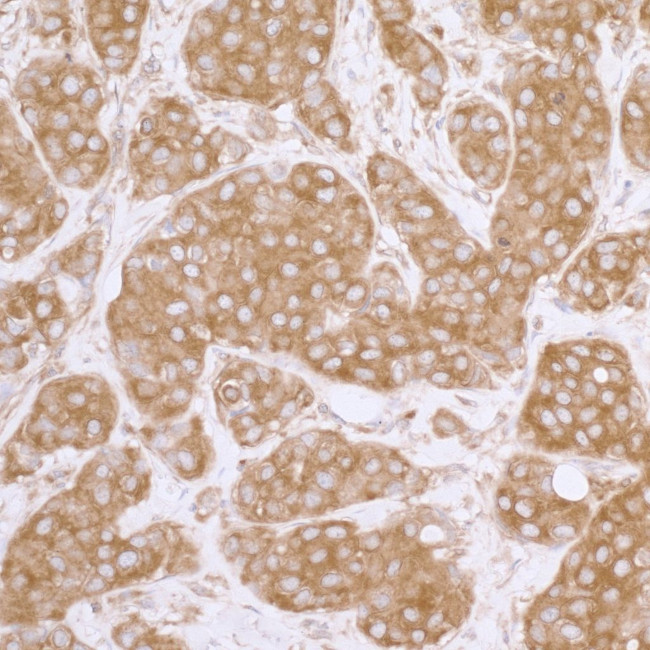
eIF3A/eIF3S10 Antibody in Immunohistochemistry (Paraffin) (IHC (P))

Search
Bethyl Laboratories
eIF3A/eIF3S10 Polyclonal Antibody
{{$productOrderCtrl.translations['antibody.pdp.commerceCard.promotion.promotions']}}
{{$productOrderCtrl.translations['antibody.pdp.commerceCard.promotion.viewpromo']}}
{{$productOrderCtrl.translations['antibody.pdp.commerceCard.promotion.promocode']}}: {{promo.promoCode}} {{promo.promoTitle}} {{promo.promoDescription}}. {{$productOrderCtrl.translations['antibody.pdp.commerceCard.promotion.learnmore']}}
图: 1 / 4
eIF3A/eIF3S10 Antibody (A302-003A) in IHC (P)




产品信息
A302-003A
种属反应
宿主/亚型
分类
类型
抗原
偶联物
形式
浓度
规格
纯化类型
保存液
内含物
保存条件
运输条件
产品详细信息
The recommended shelf life for this product is 1 year from date of receipt.
Application Note: For IHC, epitope retrieval with citrate buffer pH 6.0 or Tris-EDTA pH 9.0 is recommended for FFPE tissue sections.
Based on 100% sequence identity, this antibody is predicted to react with Rat
靶标信息
RNA-binding component of the eukaryotic translation initiation factor 3 (eIF-3) complex, which is required for several steps in the initiation of protein synthesis (PubMed:17581632, PubMed:25849773). The eIF-3 complex associates with the 40S ribosome and facilitates the recruitment of eIF-1, eIF-1A, eIF-2:GTP:methionyl-tRNAi and eIF-5 to form the 43S pre-initiation complex (43S PIC). The eIF-3 complex stimulates mRNA recruitment to the 43S PIC and scanning of the mRNA for AUG recognition. The eIF-3 complex is also required for disassembly and recycling of post-termination ribosomal complexes and subsequently prevents premature joining of the 40S and 60S ribosomal subunits prior to initiation (PubMed:17581632, PubMed:11169732). The eIF-3 complex specifically targets and initiates translation of a subset of mRNAs involved in cell proliferation, including cell cycling, differentiation and apoptosis, and uses different modes of RNA stem-loop binding to exert either translational activation or repression (PubMed:25849773, PubMed:27462815). [UniProt]
仅用于科研。不用于诊断过程。未经明确授权不得转售。
篇参考文献 (0)
生物信息学
蛋白别名: 150/170; Centrosomin; centrosomin homolog; cytoplasmic protein p167; eIF-3-theta; eIF3 p167; eIF3 p180; eIF3 p185; EIF3, p180 subunit; eIF3a; Eukaryotic translation initiation factor 3 subunit 10; EUKARYOTIC TRANSLATION INITIATION FACTOR 3 SUBUNIT 10 (EIF-3 THETA) (EIF3 P167) (EIF3 P180) (EIF3 P185) (P162 PROTEIN) (CENTROSOMIN); Eukaryotic translation initiation factor 3 subunit A; eukaryotic translation initiation factor 3, subunit 10 (theta); eukaryotic translation initiation factor 3, subunit 10 (theta, 150/170kD); eukaryotic translation initiation factor 3, subunit 10 (theta, 170kD); eukaryotic translation initiation factor 3, subunit 10 theta, 150/170kDa; eukaryotic translation initiation factor 3, subunit 10, 170kD; KIAA0139; p162; unnamed protein product
基因别名: A830012B05Rik; Csma; EIF3; eIF3-p170; eIF3-theta; EIF3A; EIF3S10; KIAA0139; mKIAA0139; P167; p180; p185; TIF32
UniProt ID: (Human) Q14152, (Mouse) P23116
Entrez Gene ID: (Human) 8661, (Mouse) 13669